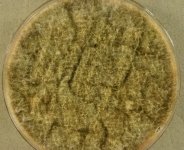

<< back to search
IMAGES:

Search Details
add to cart
| UAMH Number: | 5026 |
|---|---|
| Species Name: | Neonectria candida |
| Type: | |
| Synonyms: | Cylindrocarpon ehrenbergii / Cylindrocarpon magnusianum / Cylindrocarpon obtusiusculum / Fusarium brassicae / Fusarium candidum / Fusarium castaneum / Fusarium eichleri / Fusarium obtusiusculum / Fusarium oxysporum var. obtusiusculum / Fusarium rhizogenum / Fusidium candidum / Nectria ramulariae / Neonectria ramulariae / Ramularia candida / Sclerotium castaneum / Selenosporium brassicae |
| Taxonomy: | FUNGI Ascomycota, Sordariomycetes, Hypocreales, Nectriaceae |
| Strain History: | Sinclair, J.L. -> UAMH |
| Substrate: | subsurface groundwater bearing soil samples | Location: | USA Oklahoma (GEO: 35.008,-97.093) |
| Isolator: | J.L. Sinclair |
| Isolation Date: | |
| Date Received: | 1984-11-26 |
| Characters: | PIGMENT pink - (Click for publications citing UAMH 5026) |
| Compounds: | |
| Cross Reference: | |
| Collections: | Living Strains; Dried Herbarium Material |
| Pathogenic Potential: | Human: yes | Animal: yes | Plant: yes |
| Biosafety Risk Group: | RG2 (check the PHAC ePATHogen Risk Group Database for updates) |
| Regulatory Requirements: | Canadian requesters must provide PHAC Pathogen and Toxin License Number (see: https://www.canada.ca/en/public-health/services/laboratory-biosafety-biosecurity/licensing-program.html) prior to shipment. International requesters must provide all legally required importation documentation prior to shipment. This strain is not available for shipment to Cuba, the Democratic People's Republic of Korea, Iran or Syria. Plant pathogenicity status may be verified by using the USDA Agricultural Research Service (ARS) Fungal Database |
| MycoBank ID: | 810956 |
IMAGES: